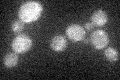
YIL155C

View description
Mitochondrial glycerol-3-phosphate dehydrogenase; expression is repressed by both glucose and cAMP and derepressed by non-fermentable carbon sources in a Snf1p, Rsf1p, Hap2/3/4/5 complex dependent manner
Localization:
Intensity:
Fold change:
Significance:
-
C’ GFP library in SD
mitochondria18.71 -
N' NOP1pr-GFP in SD

mitochondria69.7688 -
N' TEF2pr-mCherry in SD

mitochondria70.6069 -
N' NATIVEpr-GFP in SD

ambiguous32.2524 -
N' TEF2pr-VC and Cyto-VN in SD

#N/A0 -
C’ GFP library in SD+DTT

mitochondria20.311.08No -
C’ GFP library in SD+H2O2

mitochondria23.771.27No -
C’ GFP library in Starvation Media

mitochondria17.340.92No -
C’ GFP library on the background of Pup2-DaMP

mitochondria -
C’ GFP library on the background of CCT mutant

mitochondria21.94361.17253No
